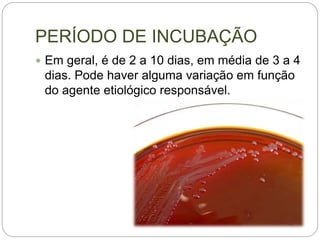
PERÍODO DE INCUBAÇÃO
 Em geral, é de 2 a 10 dias, em média de 3 a 4
dias. Pode haver alguma variação em função
do agente etiológico responsável.

O documento descreve a Neisseria meningitidis, agente causador da meningite meningocócica. Transmite-se de pessoa a pessoa por gotículas respiratórias. Crianças menores de 5 anos e maiores de 60 anos são mais suscetíveis. Os sintomas incluem febre, dor de cabeça e rigidez de nuca. O diagnóstico é feito por exame do líquido cefalorraquidiano. O tratamento envolve antibióticos e cuidados de suporte. A prevenção inclui quimioprofil